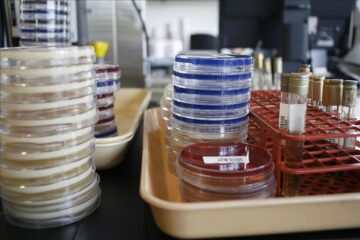
7592196w

Barcelona, 27 nov (EFE).- Cerca de medio centenar de científicos y médicos de toda España, reunidos hoy en Barcelona, impulsan la constitución de la Red Nacional para el Descubrimiento de Nuevos Antibióticos, ante el incremento de bacterias multirresistentes, que actualmente causan 25.000 muertes cada año en la Unión Europea.
Barcelona, 27 nov (EFE).- Cerca de medio centenar de científicos y médicos de toda España, reunidos hoy en Barcelona, impulsan la constitución de la Red Nacional para el Descubrimiento de Nuevos Antibióticos, ante el incremento de bacterias multirresistentes, que actualmente causan 25.000 muertes cada año en la Unión Europea.
Los doctores e investigadores Domingo Gargallo, director científico de ABAC Therapeutics; Jordi Vila, jefe del servicio de Microbiología del Hospital Clínic de Barcelona; Rafael Cantón, del Hospital Universitario Ramón y Cajal de Madrid, y Youness Ouahid, de Valoralia I+D, han explicado hoy en rueda de prensa en Barcelona la constitución de la nueva Red.
En Reino Unido y Estados Unidos, las respectivas administraciones impulsan la creación de organismos similares para la creación de nuevos medicamentos que hagan frente al grave problema de las resistencias a los actuales antibióticos, una situación que en España se produce a la inversa, como ha explicado el doctor Gargallo.
«Aquí impulsamos la Red de abajo a arriba, desde los científicos y médicos, pero es fundamental que participen todos los actores: hospitales, centros universitarios, empresas y administración, de forma consensuada y coordinada», ha considerado.
Las resistencias bacterianas suponen 2,5 millones de días de hospitalización extra al año en toda la Unión Europea, con un coste de unos 900 millones de euros, según datos facilitados hoy por estos expertos, que indican que son una amenaza grave para la salud pública.
De hecho, el Center for Disease Prevention and Control europeo ya ha advertido de esta situación, y también la Organización Mundial de la Salud (OMS) en un documento, basado en datos de 114 países, en el que también considera que la «resistencia antimicrobiana es una creciente amenaza para la salud pública».
El doctor Vila ha indicado que la evolución de la resistencia a los antibióticos va en aumento en todo el mundo y que, actualmente, «ya existen infecciones causadas por bacterias tan resistentes que son muy difíciles de tratar con los antibióticos de que disponemos y la situación irá a más si no se toman las medidas necesarias».
Ha explicado que existe una alta proporción de bacterias resistentes a los actuales antibióticos que originan infecciones comunes, como las urinarias o neumonías.
El doctor Youness Ouahid ha remarcado que el descubrimiento de nuevos antibióticos se ha ralentizado en las últimas décadas y que, de hecho, Howard Florey, codescubridor de la penicilina con Alexander Fleming, vivió para ver trece nuevas clases de antibióticos hasta su muerte, en 1968.
Desde entonces, ha precisado Ouahid, sólo se han descubierto dos nuevas clases.
La nueva Red, que se prevé estará creada en el primer trimestre del próximo año 2015, se quiere convertir en un órgano de referencia y apoyo a la administración a nivel nacional y de interlocución en los foros científicos internacionales.
«España tiene un peso importante a nivel internacional en la investigación y conocimiento dentro del campo de la Microbiología y las Enfermedades Infecciosas, y la nueva Red pretende aunar esfuerzos a nivel nacional, dando difusión a las investigaciones que se realizan aquí», ha precisado el doctor Cantón.
El futuro de los nuevos antibióticos pasa, según estos expertos, por una «medicina personalizada» o compuestos con actividad específica para cada patógeno.
La reunión para la constitución de la Red Nacional para el Descubrimiento de Nuevos Antibióticos la ha organizado en Barcelona la empresa ABAC Therapeutics, centrada en la búsqueda de antibióticos para conseguir tratamientos de precisión de las infecciones, y ha contado con el patrocinio del Grupo Ferrer, Caixa Capital Risc y CDTI (Ministerio de Economía).
